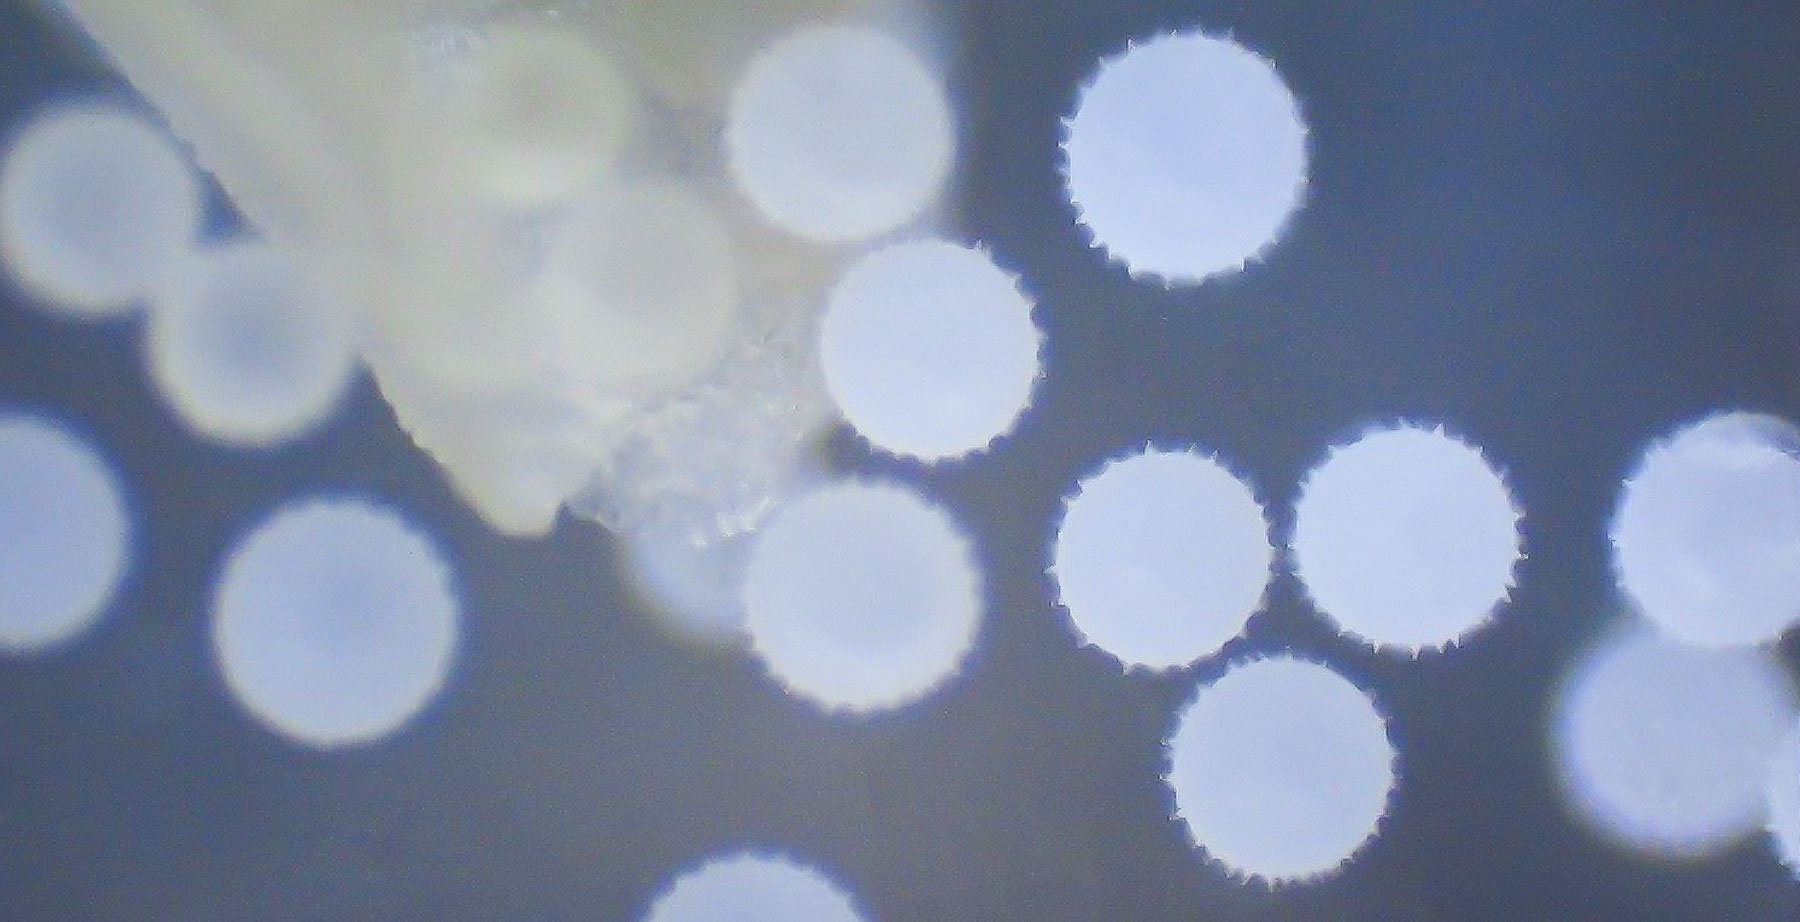

活動レポート
小学校3~6年生向け
花のつくりと花粉のひみつをさぐる
開催日時:2024年7月31日(水)13:30~15:00

2024年7月31日、一般社団法人サイエンスナビゲートの石川英雄先生が講師を務める実験教室を開催しました。対象は小学校3年生~6年生で、いろいろな花のおしべやめしべなどのつくりを観察し、種類による違いを自分の目で1つずつ確かめました。
花のつくりの観察・花粉の観察
花のつくりを観察する前に、自分が持っている「花」のイメージを学習シートに描くことから教室は始まりました。まずは花のつくりを確かめるため、今回用意された花の中からヒルガオとムクゲを選び、「花の解剖」を始めました。講師から説明を受けながら、花びらから順番に、がく、おしべ、めしべをピンセットで外してゆき、「観察シート」に貼り、形や数を調べていきました。さらに、最初に自分が描いたイメージとの違いも確かめました。また、今回は目では見えない花粉の形の違いをみるため、顕微鏡を使って観察しました。ユリの花粉はラグビーボール型をしていることや、ムクゲの花粉は丸い形で、表面に多数のトゲがあることが分かりました。
実験でわかったこと
花によって見た目は大きく違っていても、花びら、がく、おしべ、めしべといった「部分」からできていることが分かりました。また、それぞれの部分の形が違うけれど、同じ働きをすることや、花粉のような目に見えない小さなものにも違いがあることを知ることができました。